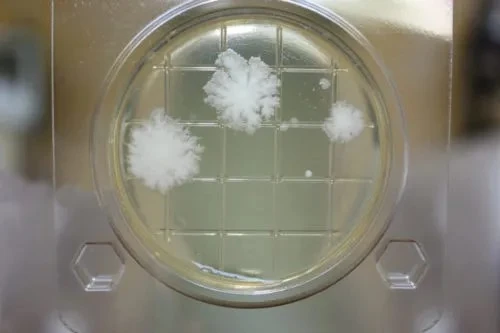

Petritest substrat xamirturush qo'ziqorinlari
ID659uz:Petritest substrat xamirturush qo'ziqorinlari
Narxi: 766 ₽
ID659uz: Petritest substrat xamirturush qo'ziqorinlari
Narxi: 766 ₽
MCHJ, ilmiy-ishlab chiqarish birlashmasi "Alternative"
Biznes
Joylashuv
Holati: Yangi
Savdo: Yoq
Tavsif
Mog'or va xamirturush uchun tezkor sinov!
Bizning sinovlarimiz oziq-ovqat mahsulotlari, oziq-ovqat xom ashyosi va boshqa namunalarni sanitariya sinovidan o'tkazishda mog'or va xamirturushlarni tezkor aniqlash uchun mo'ljallangan. Ular, shuningdek, birlamchi terish va koloniyalarni taxminiy hisoblash imkonini beradi.
Namunalar olish va ekish to'g'ridan-to'g'ri oziq-ovqat ishlab chiqarish korxonalarida amalga oshiriladi, bu esa natijalarni atigi 12-24 soat ichida tezda olishni ta'minlaydi. . Bizning testimiz maxsus yuqori sezgir xromogen muhitdan foydalanish tufayli boyitish va madaniyat izolyatsiyasining murakkab bosqichlarini chetlab o'tadi.
Natijalarni vizual tarzda oson talqin qilish baholash jarayonini sodda va sodda qiladi. Bakteriyalarni etishtirish jarayonida muhit rangining o'zgarishi tufayli tushunarli.
Petritlar qulay va ishonchli tadqiqot asboblari bo'lib, ularning har biri yopiq, sterillangan blisterga qadoqlangan. Siz maksimal gigienaga ishonchingiz komil bo'lishi mumkin, chunki atrof-muhitning atrof-muhit sporalari bilan ifloslanish xavfi yo'qoladi.
Uzoq natijalarni kutmang - tez sifat nazoratini ta'minlang. mahsulotlar. Maitrade xalqaro bepul e'lonlar saytida bizning tezkor mog'or va xamirturush sinovimizga buyurtma bering! Bizning tizimimiz biznesingizni mog'or va xamirturush bilan ifloslanishdan himoya qilishga yordam beradi. Tafsilotlar va maslahatlar uchun Mytrade.kz profilidagi kontaktlar orqali biz bilan bog‘laning.
ID: 659
Nashr etilgan 24.01.2025
53